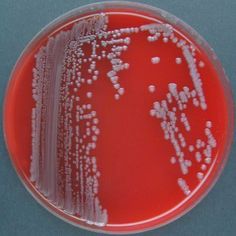

S. epidermidis: Ένα επικίνδυνο δυνητικά παθογόνο βακτήριο Ουρανία Σπυράκου – Παπακωνσταντίνου Ιατρικά
Διαγνωστικά Εργαστήρια (Αθήνα) Υπάρχουν γνωστά παθογόνα βακτήρια που αποτελούν σοβαρή απειλή για την υγεία, όμως και κάποια θεωρούμενα ως αβλαβή μπορεί να είναι εξ ίσου επικίνδυνα. Ο Staphylococcus epidermidis, που σχετίζεται φυλογενετικά με τον ανθεκτικό στη μεθικιλλίνη Staphylococcus aureus (MRSA), είναι γνωστό τα τελευταία χρόνια ότι μπορεί να προκαλέσει επικίνδυνες λοιμώξεις ιδιαίτερα μετά από προσθετικές χειρουργικές επεμβάσεις.(Otto 2009, Leitch 2018). Κι όμως οι μικροβιολόγοι έως σήμερα δεν αξιολογούν τον S. epidermidis, κυρίως γιατί είναι πανταχού παρών, επιμολύνει τα καλλιεργητικά υλικά και αποικίζει το δέρμα και τους βλεννογόνους ασυμπτωματικών ατόμων. Σε μια πρόσφατη μελέτη οι Méric et al (2018) εξέτασαν τους
υποκείμενους εξελικτικούς μηχανισμούς της ευκαιριακής παθογένειας
συγκρίνοντας μελέτες παν-γονιδιακής συσχέτισης (pan-genome-wide
association) και εργαστηριακής
μικροβιολογίας με σκοπό να διαχωρίσουν τα στελέχη S. epidermidis που
προκαλούν λοιμώξεις από τα στελέχη ασυμπτωματικών μικροβιοφορέων. Αναγνωρίστηκαν 61 γονίδια που ελέγχουν
γενετικά στοιχεία λοίμωξης (k-μερή ή k-mers)
σχετιζόμενα με in vitro γνωστά παθογόνα χαρακτηριστικά (σχηματισμός βιοφίλμ,
κυτταρική τοξικότητα, παραγωγή ιντερλευκίνης-8, αντοχή στη μεθικιλλίνη). Ο σχηματισμός
βιοφίλμ είναι μελετημένο παθογόνο χαρακτηριστικό, αφού μεταξύ των άλλων οι
κοινότητες μικροβίων του βιοφίλμ είναι γνωστό πως είναι ανθεκτικές στις
επιδράσεις των αντιβιοτικών (Εικόνα 2)
Εικόνα 2. Σχηματισμός μικροβιακού
βιοφίλμ. Στα διαγράμματα φαίνεται ότι τόσο το βιοφίλμ
στερεάς επιφάνειας (solid surface) όσο και το βιοφίλμ υμενίου (pellicle) περιέχουν εξωπολυμερείς θεμέλιες ουσίες, οι οποίες
όμως ενδέχεται να διαφέρουν ως προς τη σύνθεση (χρωματισμένες με μωβ ή
πράσινο χρώμα στην εικόνα). Δεν είναι σαφές έως σήμερα
εάν ο σχηματισμός μικροαποικιών προηγείται του σχηματισμού ώριμου βιοφίλμ
υμενίου. Τα παθογόνα
χαρακτηριστικά που ελέγχονται από τα συγκεκριμένα γονίδια έχουν την ιδιότητα
να εξαπλώνονται με οριζόντια μεταφορά, επιτρέποντας έτσι στους αποκλίνοντες
βακτηριακούς κλώνους να προκαλούν λοιμώξεις. Οι μετεγχειρητικές λοιμώξεις από δυνητικά παθογόνα στελέχη S. epidermidis είναι εξαιρετικά σοβαρές έως θανατηφόρες. Γενικά οι λοιμώξεις ευθύνονται για το 1/3 σχεδόν των θανάτων στο Ηνωμένο Βασίλειο, γι αυτό ο προεγχειρητικός έλεγχος της παρουσίας βακτηρίων που περιέχουν κάποια από τα υπεύθυνα για νόσηση γονίδια είναι χρήσιμος (Leitch 2018). Στη μελέτη των Méric et al (2018) εφαρμόστηκε το μοντέλο “τυχαίου δάσους” (random forest) για τη διάκριση της νοσηρής κατάστασης
(μικροβιοφορία έναντι λοίμωξης) σε 415 απομονωθέντα στελέχη S. epidermidis. Η ακρίβεια της πρόβλεψης έφθασε το 80%,
γεγονός που αποδεικνύει ότι υπάρχει δυνατότητα προεγχειρητικής αναγνώρισης
των γονοτύπων κινδύνου. Βιβλιογραφία Leitch C. A deadly microbe lurks on the skin of many people. Labroots, 2018, Nov 28 (Πλήρες κείμενο). Méric
G, Mageiros L, Pensar J et al. Disease-associated genotypes of the
commensal skin bacterium Staphylococcus epidermidis. Nature Communications, 2018, 9:4 (Πλήρες κείμενο). Otto
M. Staphylococcus epidermidis
– the “accidental” pathogen. Nat
Rev Microbiol, 2009, 7(8): 555-567 (Πλήρες κείμενο) ► Επιστροφή στην πρώτη σελίδα του IDEA Medical Newsletter Προειδοποίηση
Το περιεχόμενο του IDEA MEDICAL NEWSLETTER είναι επιστημονικό και απευθύνεται σε γιατρούς και λοιπούς επαγγελματίες υγείας. Σε καμιά περίπτωση δεν πρέπει να χρησιμοποιηθεί από πρόσωπα που δεν έχουν τα προσόντα νόμιμης άσκησης του ιατρικού επαγγέλματος για οποιαδήποτε θεραπευτική ή διαγνωστική εφαρμογή. |
||
|
|